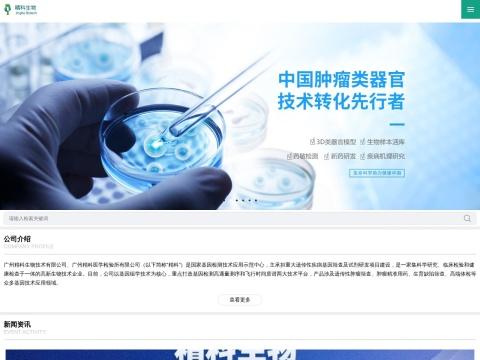
重庆精科医疗器械有限公司

重庆精科医疗器械有限公司
2162025-12-08 17:04:42
重庆精科医疗器械有限公司成立于2023年5月16日,总部位于重庆市大渡口区思源路32号9幢2-1(10号)。公司注册资本1000万元,实缴资本208万元,法定代表人为李杰。该公司是精科生物技术集团的子公司,属于小微企业,目前处于开业状态。
公司主要业务包括第二类、第三类医疗器械的生产与销售,以及医疗器械租赁、医疗服务、检验检测服务、药物临床试验服务等。核心技术集中在液相色谱-串联质谱(LC-MS/MS)平台,结合自动化样本处理与智能分析软件,为临床诊断提供高效精准的检测解决方案。
重庆精科医疗器械有限公司在临床质谱检测领域具备较强的研发实力。其明星产品 JK-LCMS-8100 超高效液相色谱串联质谱检测系统 于2024年6月获得重庆市药品监督管理局颁发的第二类医疗器械注册证,并通过欧盟CE认证。该系统可用于水溶性维生素、脂溶性维生素、激素、氨基酸、治疗药物监测及儿茶酚胺等多种临床检测项目,性能达到国内领先、国际先进水平。
地址:重庆市大渡口区思源路32号9幢2-1(10号)
电话:020-89228992
关键词:重庆精科医疗器械有限公司、精科生物、LC-MS/MS、质谱检测系统、医疗器械注册证